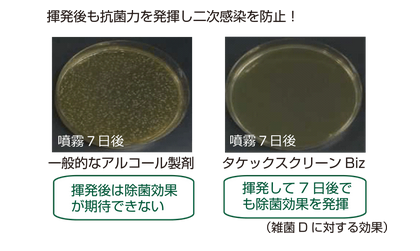

当サイトは、SSL暗号化通信
を採用しています。 |

※株式会社GREENは、タケックスの正規販売代理店です。 ※このページの内容は、株式会社セーヌライン様より許可を得て同社ウェブサイト(https://www.seineline.com) 竹の力でウイルス・雑菌を強力除去! ※環境により変化する場合もあります。
竹から抽出した「モウソウチク抽出物」を配合した唯一のアルコール製剤「タケックスクリーンBiz・77」。 「タケックスクリーンBiz・77」の特長 竹の力でウイルス・雑菌を強力除去! 
タケックスクリーンのウイルスに対する効果
タケックスクリーンに含まれる「モウソウチク抽出物」は、竹の持つ抗菌・消臭・抗酸化などの効果を抽出したエキスです。 
「タケックスクリーンBiz」は対ウイルスにおいて第三者機関で試験を行っており、以下の効果が認められました。ウイルスの99.99%以上の不活性化を実現し、その効果は最大15日間持続します。また、作用にかかる時間は約1分。その即効性も特長です。
モウソウチク抽出物のウイルスに対する効果 モウソウチク抽出物は、竹の持つ抗菌・消臭・抗酸化などの効果を抽出したエキスであり、厚生労働省からも食品添加物として認定されている、安全性の高いものです。 モウソウチク抽出物含有アルコール製剤の
鉄道チャンネル 抗菌・除菌・消臭効果のヒミツ 抗菌・消臭・抗酸化効果のあるモウソウチク抽出物。 抗菌効果

安全性

抗酸化効果

熱安定性

タケックスクリーンBiz、77が対雑菌においての第三者機関試験にて、以下の効果があることが認められました。雑菌の99%以上の不活性化を実現し、その効果は最大10日間持続します。
アルコール製剤の弱点をしっかりカバー! タケックスクリーンBiz・77は、アルコールでは効果がないウイルスや水場での効果、抗菌の持続力など、アルコール製剤ではカバーしきれないところまで効果が実証されています。
また、一般的なアルコール製剤にはない消臭効果も特長です。 幅広いウイルス除去・抗菌効果

水場にも対応できる効果

驚くべき抗菌持続力
においを元から分解・消臭

抗ウイルス持続効果試験
※すべてのウイルス・細菌に効果があるのもではありません。 「タケックスクリーンBiz・77」の5大特徴
「タケックスクリーンBiz・77」は様々なシーンで使用可能
「タケックスクリーンBiz・77」は様々なシーンで使用可能 


  |
































































